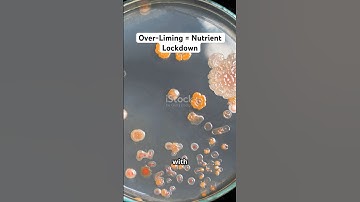
Over-Limed Soils = Micronutrient Deficiency #lime #soil #agriculture #garden #farming

⬇ DOWNLOAD NOW
Jika muncul iklan pop-up, tutup lalu klik tombol kembali
Download lagu Day 04 I Soil Physics One Shot I ASRB NET 2025 I Soil Science ASRB NET secara gratis hanya untuk keperluan promosi. Dukung artis favorit kamu dengan membeli musik original di iTunes atau platform resmi lainnya.
 Soil Physics Revision Marathon - ASRB NET 2025
Soil Physics Revision Marathon - ASRB NET 2025 Day 02 I Soil Fertility One Shot I ASRB NET 2025 I Soil Science ASRB
Day 02 I Soil Fertility One Shot I ASRB NET 2025 I Soil Science ASRB Day 01 I Soil Microbilogy One Shot I ASRB NET 2025 I Soil Science ASRB
Day 01 I Soil Microbilogy One Shot I ASRB NET 2025 I Soil Science ASRB Soil Biology One Shot for ASRB NET 2025 | ICAR JRF SRF | Complete Revision + MCQs
Soil Biology One Shot for ASRB NET 2025 | ICAR JRF SRF | Complete Revision + MCQs Hard as Rock, Silent as Soil – That’s Duripan #soil #asrbnet #study #facts #science #agriculture
Hard as Rock, Silent as Soil – That’s Duripan #soil #asrbnet #study #facts #science #agriculture ASRB NET MARATHON CLASSES | Day -6 | Soil Physics | Manisha Ma'am
ASRB NET MARATHON CLASSES | Day -6 | Soil Physics | Manisha Ma'am Over-Limed Soils = Micronutrient Deficiency #lime #soil #agriculture #garden #farming
Over-Limed Soils = Micronutrient Deficiency #lime #soil #agriculture #garden #farming Urea: Strength of Crops #urea #nitrogen fertilizer#crop #soil
Urea: Strength of Crops #urea #nitrogen fertilizer#crop #soil